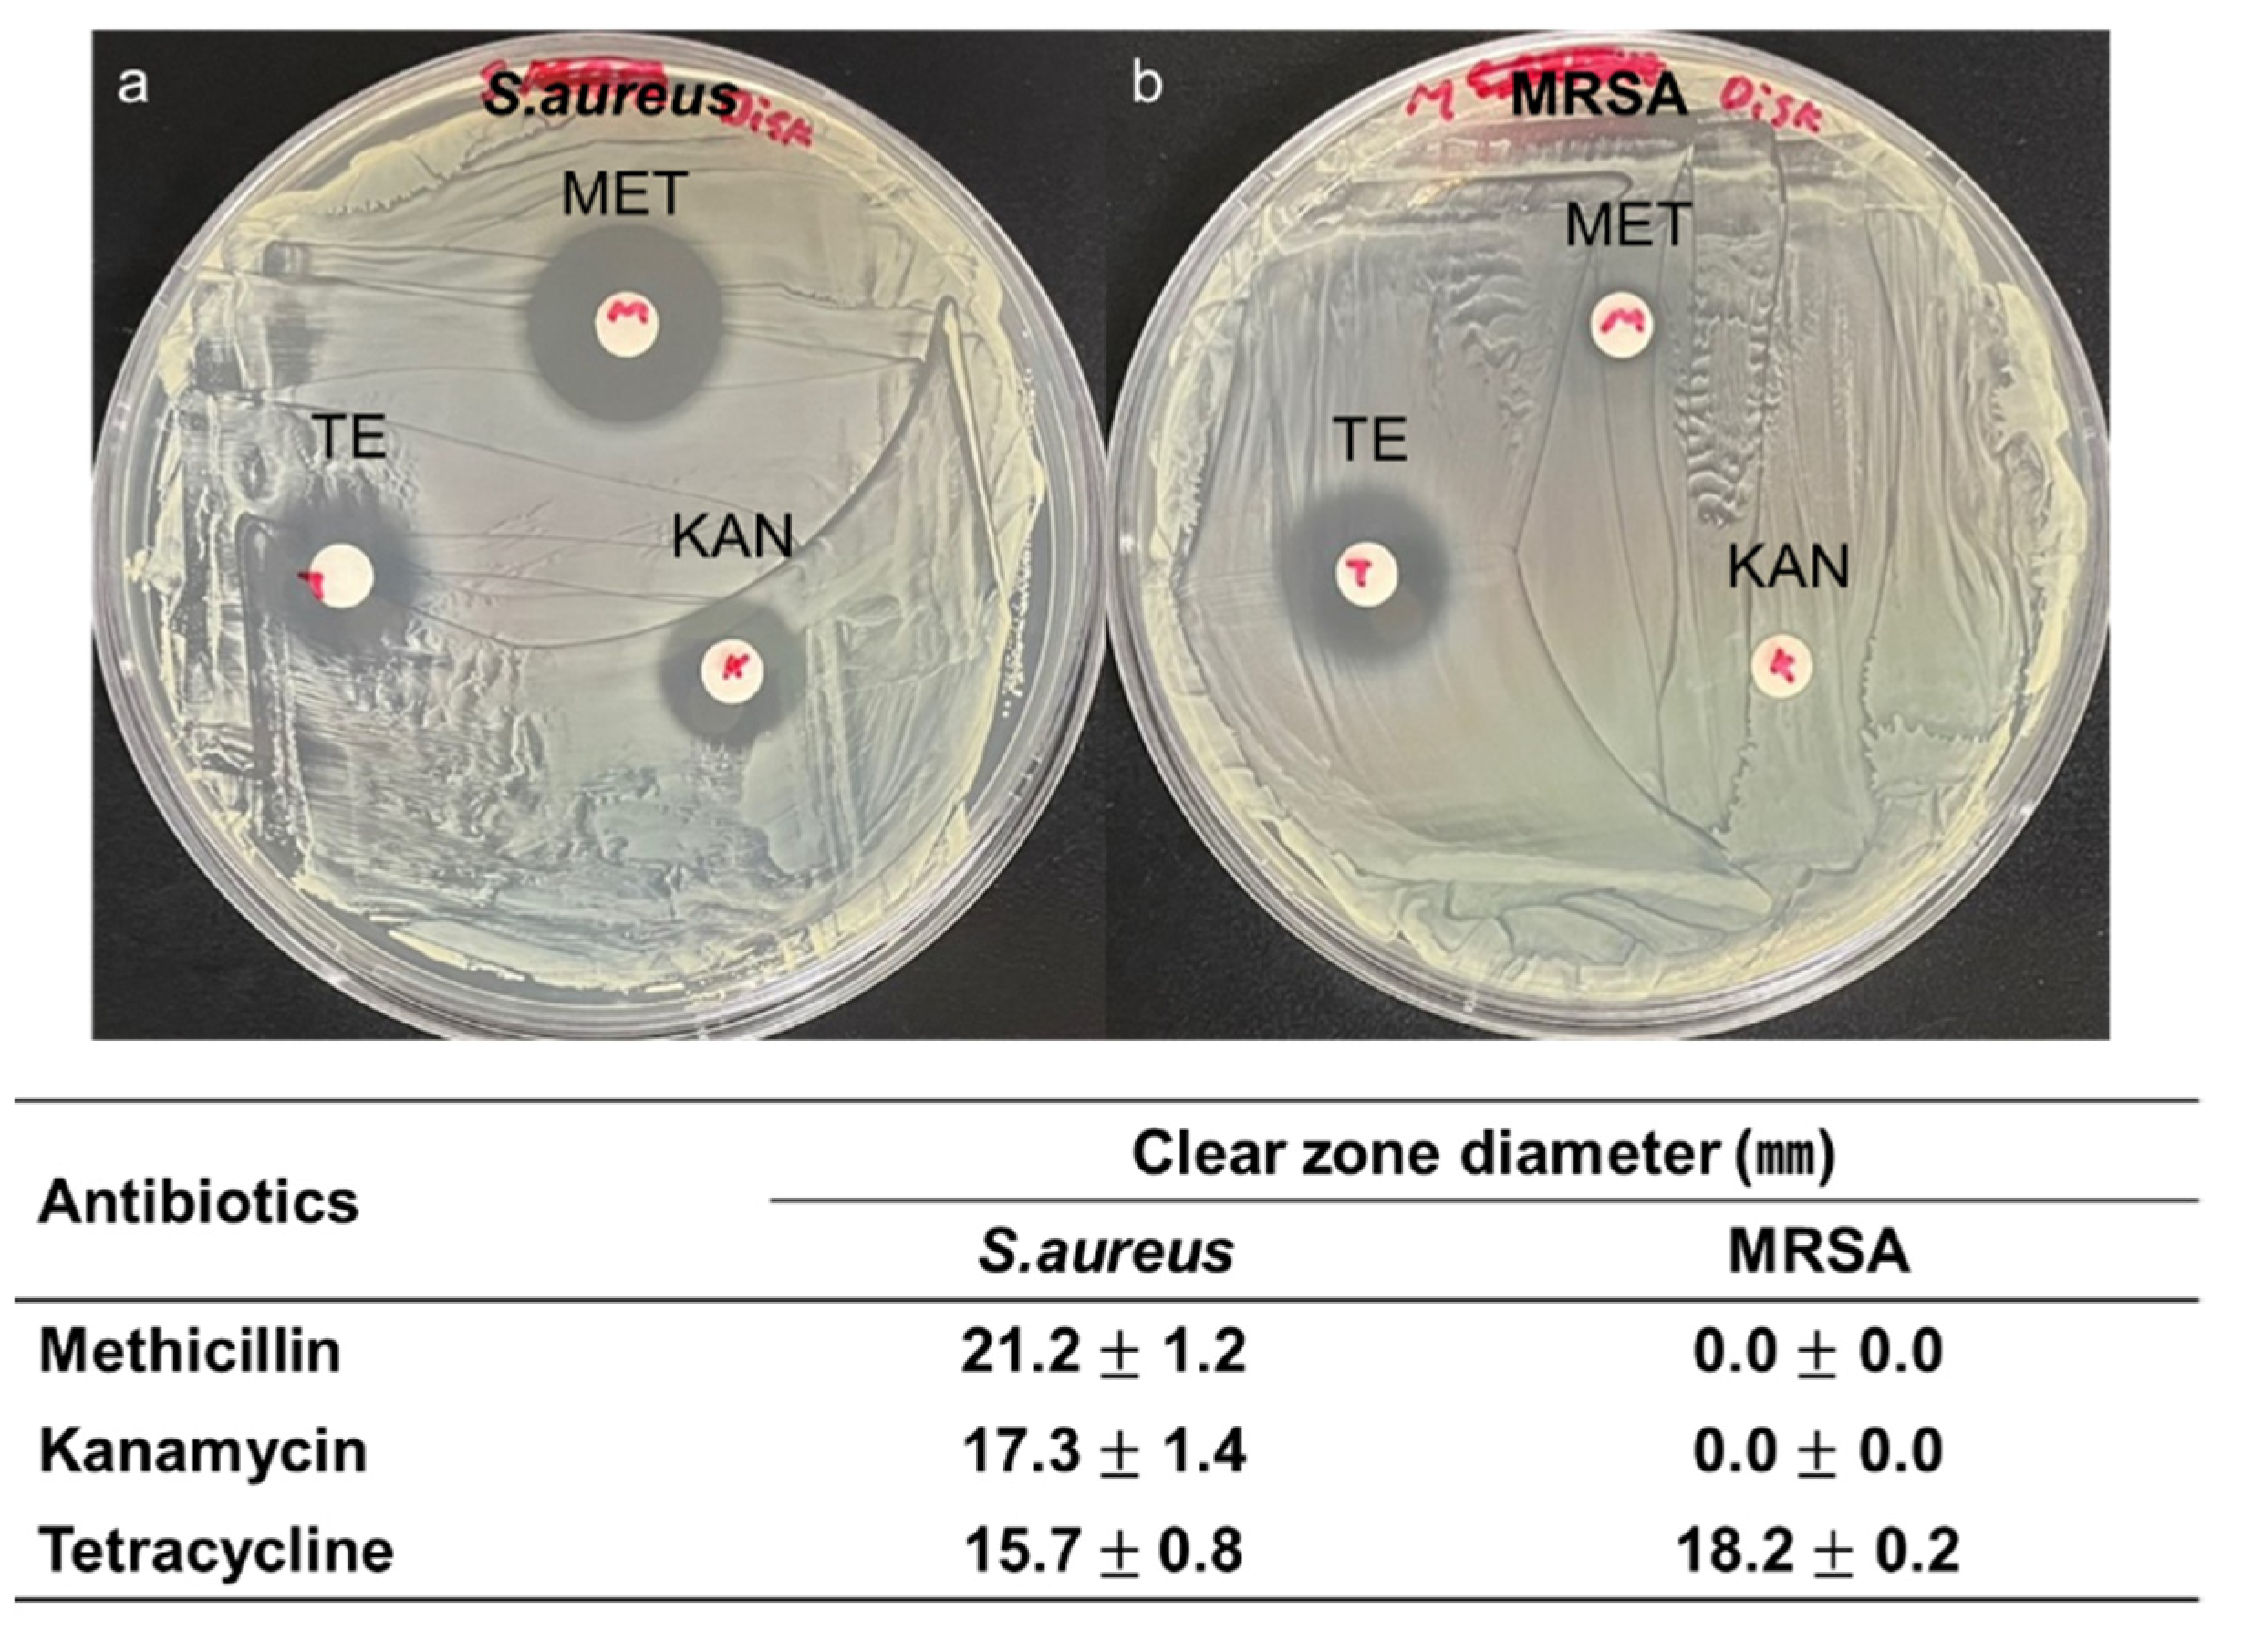
Micromachines 12 01103 g003

Cold Atmospheric Pressure Microplasma Pipette for Disinfection of Methicillin-Resistant Staphylococcus aureus
Abstract
1. Introduction
2. Methods and Analysis
2.1. Plasma Pipette
2.2. Bacteria Preparation
2.3. Plasma Treatment
3. Results
3.1. CAPMP Treatment on Bacteria in the Suspension
3.2. CAPMP Treatment on Bacteria Spread onto Agar Plate
3.3. CAPMP Treatment on Bacteria Covered by Dressing Gauze
4. Discussion
5. Conclusions
Author Contributions
Funding
Conflicts of Interest
Correction Statement
References
- Bernhardt, T.; Semmler, M.L.; Schäfer, M.; Bekeschus, S.; Emmert, S.; Boeckmann, L. Plasma Medicine: Applications of Cold Atmospheric Pressure Plasma in Dermatology. Oxid. Med. Cell. Longev. 2019, 2019, 3873928. [Google Scholar] [CrossRef] [PubMed]
- Li, D.; Li, N.; Su, X.; Liu, K.; Ji, P.; Wang, B. Continuous Phase Plate Structuring by Multi-Aperture Atmospheric Pressure Plasma Processing. Micromachines 2019, 10, 260. [Google Scholar] [CrossRef] [PubMed]
- Eswaramoorthy, N.; McKenzie, D.R. Plasma treatments of dressings for wound healing: A review. Biophys. Rev. 2017, 9, 895–917. [Google Scholar] [CrossRef] [PubMed]
- Ranjan, R.; Krishnamraju, P.V.; Shankar, T.; Gowd, S. Nonthermal Plasma in Dentistry: An Update. J. Int. Soc. Prev. Community Dent 2017, 7, 71–75. [Google Scholar] [PubMed]
- Gupta, T.T.; Ayan, H. Application of Non-Thermal Plasma on Biofilm: A Review. Appl. Sci. 2019, 9, 3548. [Google Scholar] [CrossRef]
- Lu, X.; Naidis, G.V.; Laroussi, M.; Reuter, S.; Graves, D.B.; Ostrikov, K. Reactive species in non-equilibrium atmospheric-pressure plasmas: Generation, transport, and biological effects. Phys. Rep. 2016, 630, 1–84. [Google Scholar] [CrossRef]
- Lerouge, S.; Wertheimer, M.R.; Marchand, R.; Tabrizian, M.; Yahia, L. Effect of gas composition on spore mortality and etching during low-pressure plasma sterilization. J. Biomed. Mater. Res. 2000, 51, 128–135. [Google Scholar] [CrossRef]
- Graves, D.B. Low temperature plasma biomedicine: A tutorial review. Phys. Plasmas 2014, 21, 080901. [Google Scholar] [CrossRef]
- Olatunde, O.O.; Benjakul, S.; Vongkamjan, K. Dielectric barrier discharge cold atmospheric plasma: Bacterial inactivation mechanism. J. Food Saf. 2019, 39, e12705. [Google Scholar] [CrossRef]
- Gorbanev, Y.; Privat-Maldonado, A.; Bogaerts, A. Analysis of Short-Lived Reactive Species in Plasma–Air–Water Systems: The Dos and the Do Nots. Anal. Chem. 2018, 90, 13151–13158. [Google Scholar] [CrossRef]
- Braný, D.; Dvorská, D.; Halašová, E.; Škovierová, H. Cold Atmospheric Plasma: A Powerful Tool for Modern Medicine. Int. J. Mol. Sci. 2020, 21, 2932. [Google Scholar] [CrossRef]
- Laroussi, M.; Lu, X.; Keidar, M. Perspective: The physics, diagnostics, and applications of atmospheric pressure low temperature plasma sources used in plasma medicine. J. Appl. Phys. 2017, 122, 020901. [Google Scholar] [CrossRef]
- Von Woedtke, T.; Schmidt, A.; Bekeschus, S.; Wende, K.; Weltmann, K.D. Plasma Medicine: A Field of Applied Redox Biology. In Vivo 2019, 33, 1011–1026. [Google Scholar] [CrossRef]
- Isbary, G.; Morfill, G.; Schmidt, H.; Georgi, M.; Ramrath, K.; Heinlin, J.; Karrer, S.; Landthaler, M.; Shimizu, T.; Steffes, B.; et al. A first prospective randomized controlled trial to decrease bacterial load using cold atmospheric argon plasma on chronic wounds in patients. Br. J. Dermatol. 2010, 163, 78–82. [Google Scholar] [CrossRef]
- Isbary, G.; Heinlin, J.; Shimizu, T.; Zimmermann, J.L.; Morfill, G.; Schmidt, H.U.; Monetti, R.; Steffes, B.; Bunk, W.; Li, Y.; et al. Successful and safe use of 2 min cold atmospheric argon plasma in chronic wounds: Results of a randomized controlled trial. Br. J. Dermatol. 2012, 167, 404–410. [Google Scholar] [CrossRef] [PubMed]
- Brehmer, F.; Haenssle, H.A.; Daeschlein, G.; Ahmed, R.; Pfeiffer, S.; Görlitz, A.; Simon, D.; Schön, M.P.; Wandke, D.; Emmert, S. Alleviation of chronic venous leg ulcers with a hand-held dielectric barrier discharge plasma generator (PlasmaDerm® VU-2010): Results of a monocentric, two-armed, open, prospective, randomized and controlled trial (NCT01415622). J. Eur. Acad. Dermatol. Venereol. 2015, 29, 148–155. [Google Scholar] [CrossRef] [PubMed]
- Clark, R.A. Cutaneous tissue repair: Basic biologic considerations. J. Am. Acad. Dermatol. 1985, 13, 701–725. [Google Scholar] [CrossRef]
- Henry, G.; Garner, W.L. Inflammatory mediators in wound healing. Surg. Clin. N. Am. 2003, 83, 483–507. [Google Scholar] [CrossRef]
- Nguyen, L.; Lu, P.; Boehm, D.; Bourke, P.; Gilmore, B.F.; Hickok, N.J.; Freeman, T.A. Cold atmospheric plasma is a viable solution for treating orthopedic infection: A review. Biol. Chem. 2018, 400, 77–86. [Google Scholar] [CrossRef]
- Singh, S.; Young, A.; McNaught, C.E. The physiology of wound healing. Surgery 2017, 35, 473–477. [Google Scholar] [CrossRef]
- Portela, R.; Leal, C.R.; Almeida, P.L.; Sobral, R.G. Bacterial cellulose: A versatile biopolymer for wound dressing applications. Microb. Biotechnol. 2019, 12, 586–610. [Google Scholar] [CrossRef] [PubMed]
- Alam, S.M.M.; Faruque, M.A.A.; Sarker, E.; Sowrov, K.; Alam, T.; Haque, A.N.M.A. Development of Knitted Gauze Fabric as Wound Dressing for Medical Application. Adv. Res. Text Eng. 2018, 3, 1021. [Google Scholar]
- Capanema, N.S.V.; Mansur, A.A.P.; Anderson, J.C.; Carvalho, S.M.; Oliveira, L.C.; Mansur, H.S. Superabsorbent crosslinked carboxymethyl cellulose-PEG hydrogels for potential wound dressing applications. Int. J. Biol. Macromol. 2018, 106, 1218–1234. [Google Scholar] [CrossRef] [PubMed]
- Gilotra, S.; Chouhan, D.; Bhardwaj, N.; Nandi, S.K.; Mandal, B.B. Potential of silk sericin based nanofibrous mats for wound dressing applications. Mater. Sci. Eng. C 2018, 90, 420–432. [Google Scholar] [CrossRef] [PubMed]
- Augustine, R.; Hasan, A.; Yadu, N.V.K.; Thomas, J.; Augustine, A.; Kalarikkal, N.; Moustafa, A.A.; Thomas, S. Electrospun polyvinyl alcohol membranes incorporated with green synthesized silver nanoparticles for wound dressing applications. J. Mater. Sci. Mater. Med. 2018, 29, 163. [Google Scholar] [CrossRef] [PubMed]
- Rosenbaum, A.J.; Banerjee, S.; Rezak, K.M.; Uhl, R.L. Advances in Wound Management. J. Am. Acad. Orthop. Surg. 2018, 26, 833–843. [Google Scholar] [CrossRef]
- Souza, J.M.; Henriques, M.; Teixeira, P.; Fernandes, M.M.; Fangueiro, R.; Zille, A. Comfort and Infection Control of Chitosan-impregnated Cotton Gauze as Wound Dressing. Fibers Polym. 2019, 20, 922–932. [Google Scholar] [CrossRef]
- Arroyo, A.A.; Casanova, P.L.; Soriano, J.V.; Torra i Bou, J.E. Open-label clinical trial comparing the clinical and economic effectiveness of using a polyurethane film surgical dressing with gauze surgical dressings in the care of post-operative surgical wounds. Int. Wound J. 2013, 12, 285–292. [Google Scholar] [CrossRef]
- CDC. Antibiotic Resistance Threats in the United States; Department of Health and Human Service, CDC: Atlanta, GA, USA, 2019. Available online: https://www.cdc.gov/drugresistance (accessed on 20 February 2021).
- Amin, T.B.A.; Rizvanov, A.A.; Haertlé, T.; Blatt, N.L. World Health Organization Report: Current Crisis of Antibiotic Resistance. Bionanoscience 2019, 9, 778–788. [Google Scholar]
- Daeschlein, G.; Napp, M.; Lutze, S.; Arnold, A.; von Podewils, S.; Guembel, D.; Jünger, M. Skin and wound decontamination of multidrug-resistant bacteria by cold atmospheric plasma coagulation. J. Dtsch. Dermatol. Ges. 2015, 13, 143–149. [Google Scholar] [CrossRef]
- Nicol, M.J.; Brubaker, T.R.; Honish, B.J. Antibacterial effects of low-temperature plasma generated by atmospheric-pressure plasma jet are mediated by reactive oxygen species. Sci. Rep. 2020, 10, 3066. [Google Scholar] [CrossRef] [PubMed]
- Shoda, K.; Tanaka, M.; Mino, K.; Kazoe, Y. A Simple Low-Temperature Glass Bonding Process with Surface Activation by Oxygen Plasma for Micro/Nanofluidic Devices. Micromachines 2020, 11, 804. [Google Scholar] [CrossRef]
- Hirst, A.M.; Frame, F.M.; Maitland, N.J.; Connell, D.O. Low Temperature Plasma: A Novel Focal Therapy for Localized Prostate Cancer? Biomed. Res. Int. 2014, 2014, 878319. [Google Scholar] [CrossRef] [PubMed]
- González García, L.E.; Macgregor, M.N.; Visalakshan, R.M.; Ninan, N.; Cavallaro, A.A.; Trinidad, A.D.; Zhao, Y.; Hayball, A.J.D.; Vasilev, K. Self-sterilizing antibacterial silver-loaded microneedles. Chem. Commun. 2018, 55, 171–174. [Google Scholar] [CrossRef] [PubMed]
- Kim, J.; Campbell, A.S.; de Ávila, B.E.F. Wearable biosensors for healthcare monitoring. Nat. Biotechnol. 2019, 37, 389–406. [Google Scholar] [CrossRef] [PubMed]
- Terraplasma Medical Home Page. Available online: https://www.terraplasma-medical.com (accessed on 22 February 2021).
- Wandke, D. PlasmaDerm®—Based on di_CAP Technology. In Comprehensive Clinical Plasma Medicine; Springer: Berlin/Heidelberg, Germany, 2018; pp. 495–502. [Google Scholar]
- Korzec, D.; Hoppenthaler, F.; Nettesheim, S. Piezoelectric Direct Discharge: Devices and Applications. Plasma 2021, 4, 1–41. [Google Scholar] [CrossRef]
- Femto Science Home Page. Available online: http://www.plasmapipette.com (accessed on 22 February 2021).
- Stevenson, K.; McVey, A.F.; Clark, I.B.N.; Swain, P.S.; Pilizota, T. General calibration of microbial growth in microplate readers. Sci. Rep. 2016, 6, 38828. [Google Scholar] [CrossRef]
- Wang, L.H.; Wang, M.S.; Zeng, X.A.; Liu, Z.W. Temperature-mediated variations in cellular membrane fatty acid composition of Staphylococcus aureus in resistance to pulsed electric fields. Biochim. Biophys. Acta Biomembr. 2016, 1858, 1791–1800. [Google Scholar] [CrossRef]
- Zolfaghari, P.S.; Packer, S.; Singer, M. In vivo killing of Staphylococcus aureus using a light-activated antimicrobial agent. BMC Microbiol. 2009, 9, 27. [Google Scholar] [CrossRef]
- Burts, M.L.; Alexeff, I.; Meek, E.T.; McCullers, J.A. Use of atmospheric non-thermal plasma as a disinfectant for objects contaminated with methicillin-resistant Staphylococcus aureus. Am. J. Infect. Control 2009, 37, 729–733. [Google Scholar] [CrossRef]
- Joshi, S.G.; Paff, M.; Friedman, G.; Fridman, G.; Fridman, A.; Brooks, A.D. Control of methicillin-resistant Staphylococcus aureus in planktonic form and biofilms: A biocidal efficacy study of nonthermal dielectric-barrier discharge plasma. Am. J. Infect. Control 2010, 38, 293–301. [Google Scholar] [CrossRef] [PubMed]
- Wenchao, Z.; Qing, L.; Ximing, Z.; Yikang, P. Characteristics of atmospheric pressure plasma jets emerging into ambient air and helium. J. Phys. D Appl. Phys. 2009, 42, 202002. [Google Scholar]
- Fridman, G.; Brooks, A.D.; Balasubramanian, M.; Fridman, A.; Gutsol, A.; Vasilets, V.N.; Ayan, H.; Friedman, G. Comparison of Direct and Indirect Effects of Non-Thermal Atmospheric-Pressure Plasma on Bacteria. Plasma Processes Polym. 2007, 4, 370–375. [Google Scholar] [CrossRef]
- Sato, T. Sterilization mechanism for Escherichia coli by plasma flow at atmospheric pressure. Appl. Phys. Lett. 2006, 89, 073902. [Google Scholar] [CrossRef]
- Hu, M.; Guo, Y. The sterilization of Escherichia coli by dielectric-barrier discharge plasma at atmospheric pressure. Appl. Surf. Sci. 2011, 257, 7065–7070. [Google Scholar]

Publisher’s Note: MDPI stays neutral with regard to jurisdictional claims in published maps and institutional affiliations. |
© 2021 by the authors. Licensee MDPI, Basel, Switzerland. This article is an open access article distributed under the terms and conditions of the Creative Commons Attribution (CC BY) license (https://creativecommons.org/licenses/by/4.0/).
Share and Cite
Nam, G.; Kim, M.; Jang, Y.; Cho, S. Cold Atmospheric Pressure Microplasma Pipette for Disinfection of Methicillin-Resistant Staphylococcus aureus. Micromachines 2021, 12, 1103. https://doi.org/10.3390/mi12091103
Nam G, Kim M, Jang Y, Cho S. Cold Atmospheric Pressure Microplasma Pipette for Disinfection of Methicillin-Resistant Staphylococcus aureus. Micromachines. 2021; 12(9):1103. https://doi.org/10.3390/mi12091103
Chicago/Turabian StyleNam, Geunyoung, Muhwan Kim, Yeonsook Jang, and Sungbo Cho. 2021. "Cold Atmospheric Pressure Microplasma Pipette for Disinfection of Methicillin-Resistant Staphylococcus aureus" Micromachines 12, no. 9: 1103. https://doi.org/10.3390/mi12091103
APA StyleNam, G., Kim, M., Jang, Y., & Cho, S. (2021). Cold Atmospheric Pressure Microplasma Pipette for Disinfection of Methicillin-Resistant Staphylococcus aureus. Micromachines, 12(9), 1103. https://doi.org/10.3390/mi12091103

